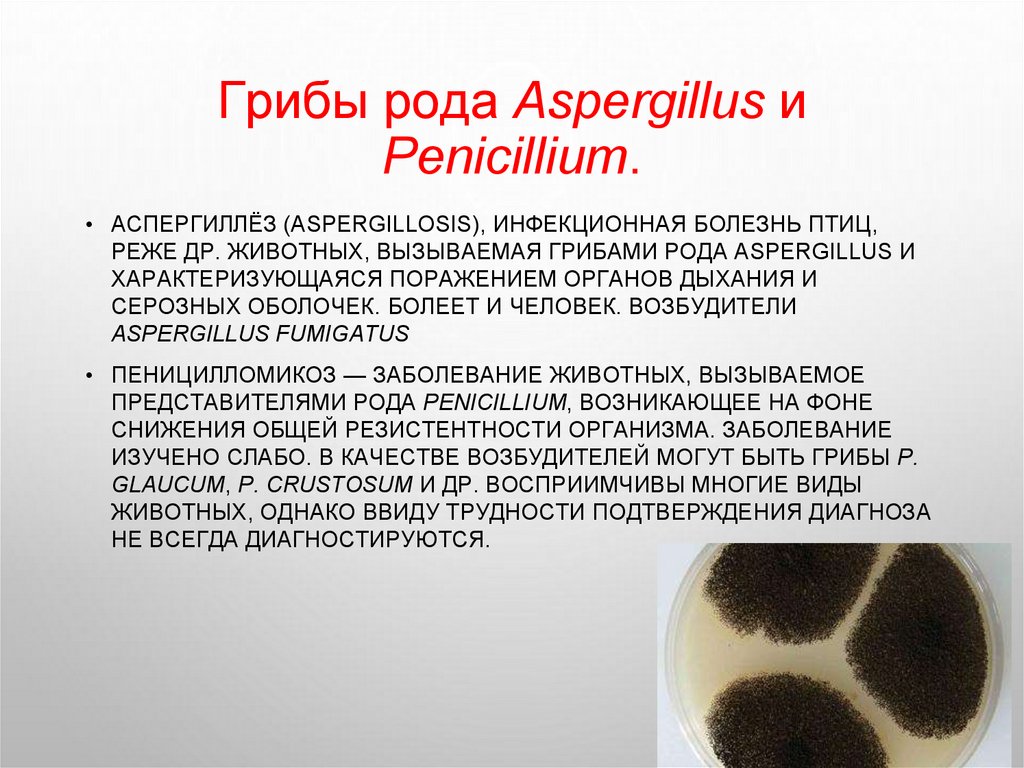

Similar presentations:
Морфология грибов. Мицелиальные грибы, дрожжевые грибы и актиномицеты
1.
НЕКОММЕРЧЕСКОЕ АКЦИОНЕРНОЕ ОБЩЕСТВОКАЗАХСКИЙ НАЦИОНАЛЬНЫЙ АГРАРНЫЙ ИССЛЕДОВАТЕЛЬСКИЙ УНИВЕРСИТЕТ
ФАКУЛЬТЕТ ВЕТЕРИНАРИЯ
КАФЕДРА МИКРОБИОЛОГИЯ, ВИРУСОЛОГИЯ И ИММУНОЛОГИЯ
ЛАБОРАТОРНОЕ ЗАНЯТИЕ № 3
ТЕМА: МОРФОЛОГИЯ ГРИБОВ.
МИЦЕЛИАЛЬНЫЕ ГРИБЫ, ДРОЖЖЕВЫЕ
ГРИБЫ И АКТИНОМИЦЕТЫ
2.
Цель занятия:Научится дифференцировать эукариоты. Ознакомиться со
строение грибов (дрожжи, плесневые грибы: мукор, аспергилы и
пенициллиум)
Вопросы:
1. Морфология
мицелиальных
грибов
(мукоровых,
аспергиловых и пенициллиновых).
2. Морфология дрожжевых грибов.
3. Изучение морфологии актиномицетов
3.
Грибы - это растительные, гетеротрофные эукариотические организмы.Для них характерно более сложное строение, чем у бактерий и более
совершенные способы размножения.
В клетке грибов содержится: ядро, цитоплазма с органоидами и мощная
клеточная стенка, состоящая их нескольких типов полисахаридов,
белков и липидов. Основу составляет хитин. Мембрана содержит
фосфолипиды и стеролы.
По морфологии различают грибы:
-нитевидные или плесени (мицелиальные). Тело которых состоит из
длинной нити, разделенной перегородкой у отдельной клетки, у высших
грибов. У низших грибов, нити (гифы) мицелия не образуют перегородок;
-грибы дрожжи (одноклеточные организмы овальной формы).
4.
МИКРОСКОПИЧЕСКИЕГРИБЫ
■
■
■
■
■
Одно- или многоклеточные
безхлорофильные растительные
микроорганизмы, являющиеся эукариотами
Относятся к царству Fungi (Mycetes, Mycota)
Различают гифальные (2-100 мкм ) и дрожжевые (25 мкм) грибы.
По строению
– низшие
(без перегородок) и
высшие (септированные)
По характеру размножения – совершенные
(половое размножение) и несовершенные (бесполое
размножение).
5.
6.
7.
8.
ГИФАЛЬНЫЕ ГРИБЫГифальные (плесневые) грибы образуют ветвящиеся тонкие нити (гифы),
сплетающиеся в грибницу или мицелий (плесень). Толщина гиф колеблется от 2 до
100 мкм.
Гифы, врастающие в питательный субстрат, называются вегетативными гифами
(отвечают за питание гриба), а растущие над поверхностью субстрата –
воздушными или репродуктивными гифами (отвечают за бесполое размножение).
Гифы низших грибов не имеют перегородок. Они представлены многоядерными
клетками и называются ценоцитными (от греч. koenos– единый, общий).
Гифы высших грибов разделены перегородками или септами с отверстиями.
9.
Дрожжевые грибыДрожжевые грибы (дрожжи), в основном,
имеют вид отдельных овальных клеток
(одноклеточные грибы).
По
полового размножения
они
распределены
т
среди высших грибов ипу
аскомицет и базидиомицет.
При
бесполом
размножении
дрожжи
образуют почки или делятся, что приводит
к одноклеточному росту.
Могут образовывать псевдогифы и ложный
мицелий (псевдомицелий) в виде цепочек
удлиненных клеток – «сарделек».
Грибы
аналогичные
дрожжам,
полового способа
размножения,
,
но
не
дрожжеподобными.
Они
имеющие
размножаютс
только бесполым
называют
почкованием
или делением.
я
способом
–
Понятие
«дрожжеподобныегрибы»
часто
идентифицируют с понятием «дрожжи».
10.
11.
Диморфизм грибов12.
13.
14.
Типы грибов, имеющих значение в ветеринарии■
Выделяют три типа грибов, имеющих половой способ
размножения (так называемые, совершенные грибы):
зигомицеты (Zygomycota), аскомицеты (Ascomycota)
и базидиомицеты (Basidiomycota).
Отдельно выделяют условный, формальный
группу
грибов
–
дейтеромицеты
тип или
(Deiteromycota),
которых
имеется
только
бесполый
у
способ
размножения (так называемые,
несовершенные грибы)
■
15.
ЗИГОМИЦЕТЫЗигомицеты относятся к низшим грибам
(мицелий несептированный). Они включают
представителей
родов
Mucor, Rhizopus,
Rhizomucor, Absidia, Basidiobolus, Conidiobolus .
Распространены в почве и воздухе.
Могут
вызывать
зигомикоз
(мукоромикоз) у животных.
При бесполом размножении зигомицет
на
плодоносящей
гифе
(спорангиеносец)
образуется
спорангий
– шаровидное
утолщение
с
оболочкой, содержащее
многочисленные
спорангиоспоры.
Половое
размножение
у
зигомицет происходит
с помощью зигоспор.
Зигомикоз у собак и кошек.
Изъязвлённые узелки у собаки.
16.
АСКОМИЦЕТЫАскомицеты ( сумчатые грибы) имеют септированный мицелий ( кроме
одноклеточных дрожжей). Свое название они получили от основного органа
плодоношения – сумки, или аска, содержащего 4 или 8 гаплоидных половых спор
(аскоспор).
К аскомицетам относятся отдельные представители (телеоморфы) родов
Aspergillus и Penicillium.
Большинство грибов родов Aspergillus и Penicillium являются анаморфами, т.е.
размножаются только бесполым путем, с помощью бесполых спор – конидий и
должны быть отнесены по этому признаку к несовершенным грибам
17.
Грибы рода Аspergillus иРenicillium.
• АСПЕРГИЛЛЁЗ (ASPERGILLOSIS), ИНФЕКЦИОННАЯ БОЛЕЗНЬ ПТИЦ,
РЕЖЕ ДР. ЖИВОТНЫХ, ВЫЗЫВАЕМАЯ ГРИБАМИ РОДА ASPERGILLUS И
ХАРАКТЕРИЗУЮЩАЯСЯ ПОРАЖЕНИЕМ ОРГАНОВ ДЫХАНИЯ И
СЕРОЗНЫХ ОБОЛОЧЕК. БОЛЕЕТ И ЧЕЛОВЕК. ВОЗБУДИТЕЛИ
ASPERGILLUS FUMIGATUS
• ПЕНИЦИЛЛОМИКОЗ — ЗАБОЛЕВАНИЕ ЖИВОТНЫХ, ВЫЗЫВАЕМОЕ
ПРЕДСТАВИТЕЛЯМИ РОДА PENICILLIUM, ВОЗНИКАЮЩЕЕ НА ФОНЕ
СНИЖЕНИЯ ОБЩЕЙ РЕЗИСТЕНТНОСТИ ОРГАНИЗМА. ЗАБОЛЕВАНИЕ
ИЗУЧЕНО СЛАБО. В КАЧЕСТВЕ ВОЗБУДИТЕЛЕЙ МОГУТ БЫТЬ ГРИБЫ Р.
GLAUCUM, Р. CRUSTOSUM И ДР. ВОСПРИИМЧИВЫ МНОГИЕ ВИДЫ
ЖИВОТНЫХ, ОДНАКО ВВИДУ ТРУДНОСТИ ПОДТВЕРЖДЕНИЯ ДИАГНОЗА
НЕ ВСЕГДА ДИАГНОСТИРУЮТСЯ.
18.
ДРОЖЖЕВЫЕАСКОМИЦЕТЫ
Представителями аскомицетов являются также дрожжи (роды Saccharomyces,
телеоморфы многих видов Candida).
Дрожжи – одноклеточные грибы, утратившие способность к образованию
истинного мицелия; имеют овальную форму клеток диаметром 3-15 мкм. Они
размножаются почкованием, бинарным делением на две равные клетки или
половым путем с образованием аскоспор.
Заболевания, вызываемые некоторыми видами дрожжей, получили название
дрожжевых микозов (напр., гистоплазмоз)
19.
Базидиомицеты(шляпочные
грибы) имеют септированный
Базидиомицеты
мицелий.
Они образуют
половые
споры базидиоспоры
отшнуровывания от базидия – путем
концевой клетки мицелия, гомологичной
аску.
К
базидиомицетам
относятся
некоторые
дрожжи,
например,
телеоморфы Cryptococcus neoformans
Криптококкоз – это инфекционное заболевание, вызываемое
дрожжеподобным грибком Cryptococcus neoformans. Болеют многие виды
животных, в том числе собаки и кошки, а также человек
20.
ДЕЙТЕРОМИЦЕТЫДейтеромицеты (несовершенные грибы,
Fungi
imperfecti, анаморфные
грибы,
грибы)
являются
условным, формальным типом грибов, который
конидиальные
объединяет грибы, не имеющие полового размножения.
Слово «формальный» означает, что потенциально эти
грибы могут иметь половой способ размножения; при
установлении последнего факта, грибы переносятся в
один из известных типов - Ascomycota или Basidiomycota
и им присваивают название телеоморфной формы.
21.
ДРОЖЖЕПОДОБНЫЕДЕЙТЕРОМИЦЕТЫ
относятс
К
дейтеромицетам
я дрожжи
несовершенные
например
грибы),
(дрожжеподобны
рода , Candida,
некоторые
е
грибыкожу, слизистые оболочки и
поражающие
внутренние органы (кандидоз).
Они имеют овальную форму, диаметр
2-5 мкм, делятся почкованием, образуют
псевдогифы (псевдомицелий)
в виде
цепочек из удлиненных клеток; иногда
образуют гифы.
Для Candida albicans характерно
образование хламидоспор.
22.
ИЗУЧЕНИЕ МОРФОЛОГИЧЕСКИХСВОЙСТВ ГРИБОВ
Изучение морфологических и
тинкториальных свойств грибов
проводится микроскопическим
методом в нативных и
окрашенных мазках. Для окраски
мазков чаще всего используют
простые методы окраски
(метиленовый синий), а также
методы Грама, Циля –
Нильсена, Романовского-Гимза.
При микроскопии обращают
внимание на строение мицелия и
органов спороношения. Также
обращают внимание на форму
дрожжевых клеток, наличие
почковидных выпячиваний,
23.
Актиномицеты• Актиномицеты – «лучистые грибки» морфология:
палочки или ветвистые клетки, грам + , имеется
несептированный мицелий. Структура – как у бактерий
размножение спорами, почкованием, фрагментацией
мицелия. В отличие от грибов, актиномицеты имеют
прокариотическое строение клетки, не содержат в
клеточной стенке хитина или целлюлозы, размножаются
только бесполым путем. У низших актиномицетов
мицелий фрагментируется на типичные одноклеточные
бактерии. Мицелий актиномицетов подразделяют на
субстратный
(в
субстрате)
и
воздушный.
К
мицелиальным бактериям относят микобактерии, род
накардий и актиномицетов, несколько родов высших
актиномицет.
Факультативные анаэробы протео- и липолитическая
активность. Высокая устойчивость во внешней среде.
• Актиномикоз - хроническая болезнь домашних и диких
животных,
характеризующаяся
образованием
соединительнотканных плотных узлов (актиномиком) в
различных органах и тканях.
Актиномицеты окрашенные по
Граму

biology
biology








